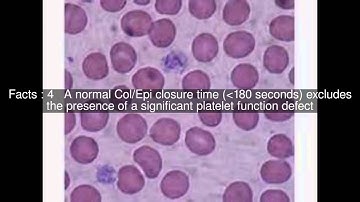
PFA-100 Top  #7 Facts

⬇ DOWNLOAD NOW
Kalau muncul iklan pop-up, tutup lalu klik tombol kembali
Download lagu The Platelet Function Analyzer PFA-100® System secara gratis hanya untuk keperluan promosi. Dukung artis favorit kamu dengan membeli musik original di iTunes atau platform resmi lainnya.
 Platelet function assay
Platelet function assay
 Platelet Function Tests, “ANYSIS”
Platelet Function Tests, “ANYSIS”
 Platelet function analyzer: Aspirin test, P2Y12 test, ADP and Epinephrine test
Platelet function analyzer: Aspirin test, P2Y12 test, ADP and Epinephrine test
 Platelet function test test kit demo
Platelet function test test kit demo
 PFA-100
PFA-100
PFA-100 Top #7 Facts
PFA-100 Top #7 Facts
 Platelet Activation and Factors for Clot Formation
Platelet Activation and Factors for Clot Formation
 PFA Introduction Video
PFA Introduction Video